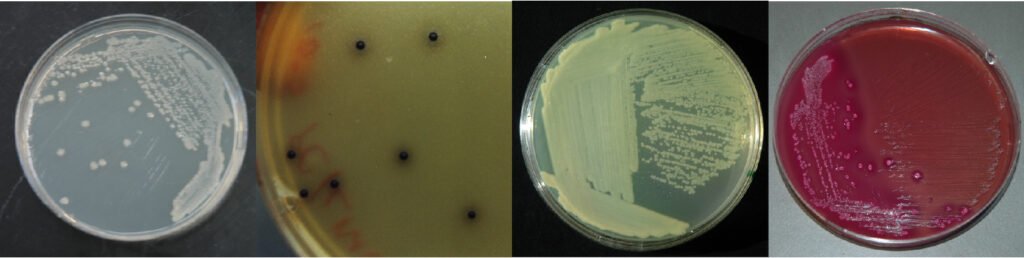
Growth of bacteria on various plates

Tired of paying high prices for your textbook? Feeling guilty for asking your students to shell out hundreds of dollars to get a decent reference to supplement your course? Well, so was I! (I am Professor Timothy Paustian by the way.) I have taught microbiology for over 30 years, and in that time, I have seen textbook prices skyrocket at rates much higher than the rate of inflation. When I was in college (it wasn’t that long ago), a good-quality textbook cost $30. Today, a good quality textbook will cost you $200.00, and if you get it at the bookstore, it will be even more! Well, I got tired of this and decided to write one myself. With the help of Gary Roberts, we created Through the Microscope, a brand-new textbook written on and for the web. It contains 30 chapters covering general microbiology, biochemistry, genetics, microbial diversity, pathogenesis, and disease, and more. This is not just a hardcover textbook that has been moved over to a website. This was designed from the ground up to live on the web and take advantage of all the multimedia and interactive possibilities a website can create. Want some examples? Click on any link in the bullet list below.
- Animations showing how enzymes speed up reactions.
- A demonstration of how chemical energy in NADH + H+ is converted into a proton motive force.
- A search function allowing you to find any topic that the book might cover. Try searching for ATP or your favorite microbe. Note that this will only show you results from Chapters 1, 2, 3, 15, and 16, which are open to the public.
- A pop-up glossary. When reading a page, words that are defined in the glossary appear with a green highlighted background. If you mouse over those words, a definition pops up. Try it out in the history section on Robert Koch. You may need to scroll down a little to see some glossary words.
Well, this all sounds great, but how much? A one-year subscription to the website is $30. If you are teaching a microbiology course, consider saving your students some cash and getting a top-quality textbook.
If you are an instructor interested in reviewing the book, just ask for a free subscription by filling out the contact form: